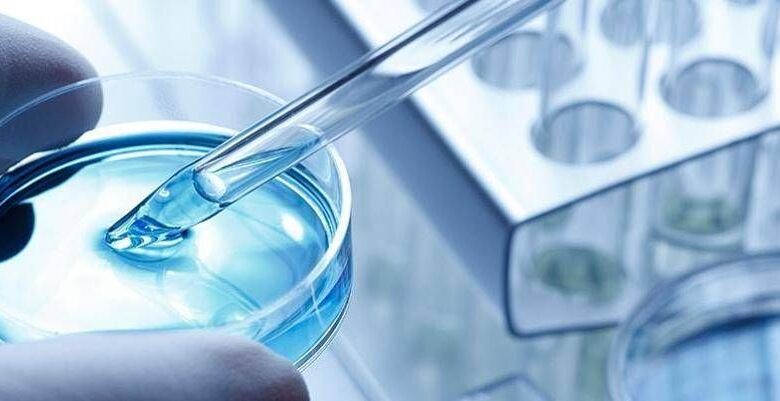

Infezioni multiresistenti, nuovi dati confermano efficacia cefiderocol
(Adnkronos) – In occasione del 36° Congresso della Società europea di microbiologia clinica e malattie infettive (Escmid), in corso a Monaco di Baviera fino al 21 aprile, Shionogi ha presentato nuovi dati di real-world evidence su cefiderocol, cefalosporina siderofora di ultima generazione, in pazienti adulti con infezioni gravi causate da Enterobacterales produttori di metallo-beta-lattamasi (Mbl), patogeni Gram-negativi multiresistenti largamente diffusi in Italia, specie in ambito ospedaliero. Come riporta una nota, lo studio Circe – retrospettivo, osservazionale, multicentrico condotto tra gennaio 2023 e aprile 2025 – ha evidenziato che il 68% dei pazienti trattati con cefiderocol aveva raggiunto la guarigione clinica al giorno 14 e che l’82% presentava una risposta clinica positiva allo stesso timepoint. I tassi complessivi di sopravvivenza risultavano pari al 90% al giorno 14 e all’83% al giorno 28. Al basale, il 29% dei pazienti era immunodepresso, il 27% ricoverato in terapia intensiva e il 13% presentava shock settico.
Gli Enterobacterales produttori di Mbl – spiega l’azienda – inattivano quasi tutti gli antibiotici beta-lattamici, compresi i carbapenemi, farmaci solitamente riservati alle infezioni gravi o ad alto rischio, limitando così le opzioni terapeutiche. Nello studio Circe, i patogeni resistenti ai carbapenemi identificati con maggiore frequenza sono stati rispettivamente Klebsiella pneumoniae ed Enterobatteri spp, entrambi classificati dall’Organizzazione mondiale della sanità come patogeni ad alta priorità a causa dei loro elevati livelli di resistenza alle terapie attualmente disponibili.
“Le infezioni sostenute da Enterobacterales produttori di Mbl rappresentano una sfida clinica significativa e crescente a livello globale, in particolare nei pazienti in condizioni critiche per i quali le opzioni terapeutiche rimangono ancora limitate – afferma Ricard Ferrer, Head of the Intensive Care Department del Vall d’Hebron Hospital di Barcellona, Spagna – Questi risultati confermano l’efficacia clinica di cefiderocol nei pazienti adulti e forniscono ulteriori evidenze di real-world che potranno orientare le future scelte terapeutiche”. Tra i pazienti per i quali erano disponibili colture di follow-up, i tassi di eradicazione microbiologica sono risultati pari all’85% nelle infezioni del flusso sanguigno e all’82% nelle infezioni del tratto urinario. Circa la metà dei pazienti è stata trattata con cefiderocol sulla base dei risultati dei test di sensibilità.
Ulteriori dati presentati all’Escmid 2026 – riferisce Shionogi -hanno valutato l’attività antimicrobica in vitro di cefiderocol nei confronti di oltre 4mila isolati di Stenotrophomonas maltophilia da campioni clinici raccolti nell’ambito dei programmi di sorveglianza multinazionali Sider0-Wt (2014-2019) e Sentry (2020-2024). In questo periodo di 10 anni, cefiderocol ha dimostrato un’attività in vitro costantemente elevata, senza evidenza di cambiamenti significativi nei profili di sensibilità prima o dopo la commercializzazione. Lo Stenotrophomonas maltophilia rappresenta un patogeno opportunistico con resistenza intrinseca a diverse classi di antimicrobici, una condizione che spesso limita le opzioni terapeutiche nei pazienti ad alto rischio.
“I dati derivanti da ampi programmi di sorveglianza internazionali rivestono un ruolo fondamentale per fornire dati epidemiologici sull’andamento delle sensibilità agli antimicrobici nel tempo – commenta Stefania Stefani, professore ordinario di Microbiologia dell’università di Catania e past president della Società italiana di microbiologia (Sim) – L’attività in vitro costantemente elevata di cefiderocol osservata nei confronti di Stenotrophomonas maltophilia nell’arco di un decennio, rappresenta un’evidenza microbiologica di rilievo per un patogeno caratterizzato da un noto e complesso profilo di resistenza intrinseca”. Ulteriori dati presentati hanno confermato l’efficacia nella pratica clinica di cefiderocol nei confronti di questo bacillo gram-negativo multiresistente: un’analisi di sottogruppo su 119 pazienti dello studio Prove ha dimostrato la guarigione clinica in circa due terzi dei pazienti, la maggior parte dei quali era in condizioni critiche e ricoverata in unità di terapia intensiva.
“La resistenza antimicrobica rimane una delle principali minacce globali per la gestione delle infezioni gravi da Gram‑negativi. In questo contesto – conclude Mark Hill, Global Head of Medical Affairs di Shionogi – i dati presentati contribuiscono ad ampliare il corpus di evidenze scientifiche a supporto di cefiderocol nei patogeni resistenti e rafforzano l’importanza di un impegno costante nell’innovazione e nella ricerca clinica in ambito antimicrobico”.
—
salute
webinfo@adnkronos.com (Web Info)




